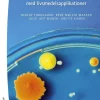
Grundläggande mikrobiologi med livsmedelsapplikationer -

Grundläggande mikrobiologi med livsmedelsapplikationer –
kr664.37
$65.52
Grundläggande mikrobiologi med livsmedelsapplikationer ger en god förståelse av olika mikroorganismer, deras tillväxt och funktioner och roll vid produktion av livsmedel. Bokens första del innehåller en ingående genomgång av den moderna systematiska bakteriologin och dessutom beskrivs virus, svampar, protozoer och parasiter. Andra delen ger en grundlig introduktion i produktion av livsmedel, mikrobiologiska risker och konserveringsmetoder och hur man kan arbeta med livsmedelssäkerhet så att mikroorganismer inte blir en hälsorisk.
Boken är en översättning från danska och innehållet har anpassats efter svensk lagstiftning och svenska förhållande då exempelvis förekomsten av patogener till viss del skiljer sig mellan Sverige och Danmark. Denna tredje upplaga är uppdaterad och ingående reviderad. Bland annat finns nu avsnitt om biofilm och tarmens mikrobiota. Kapitlen om livsmedelssäkerhet har utvidgats så att det kan användas som uppslagsbok för livsmedelsföretag. Slutligen har boken fått en helt ny layout med illustrationer i färg.
Grundläggande mikrobiologi med livsmedelsapplikationer lämpar sig för introducerande högskole- och universitetsstudier i ämnet, i första hand på utbildningar med livsmedelsanknytning. Den kan även med fördel användas som fortbildningslitteratur inom exempelvis livsmedelsindustrin.
- Författare: Herluf Thougaard, Rene Møller Madsen, Julie Just Munch, Anette Kamuk
- Format: Häftad
- ISBN: 9789144160368
- Språk: Svenska
- Antal sidor: 459
- Utgivningsdatum: 2023-08-01
- Översättare: Anna Blücher
- Förlag: Studentlitteratur AB
Be the first to review “Grundläggande mikrobiologi med livsmedelsapplikationer –” Avbryt svar
Related products
Ämnen A-Ö
Ämnen A-Ö
Ämnen A-Ö
Ämnen A-Ö
Ämnen A-Ö
Ämnen A-Ö
Ämnen A-Ö
Ämnen A-Ö
Ämnen A-Ö
Ämnen A-Ö

Reviews
There are no reviews yet.